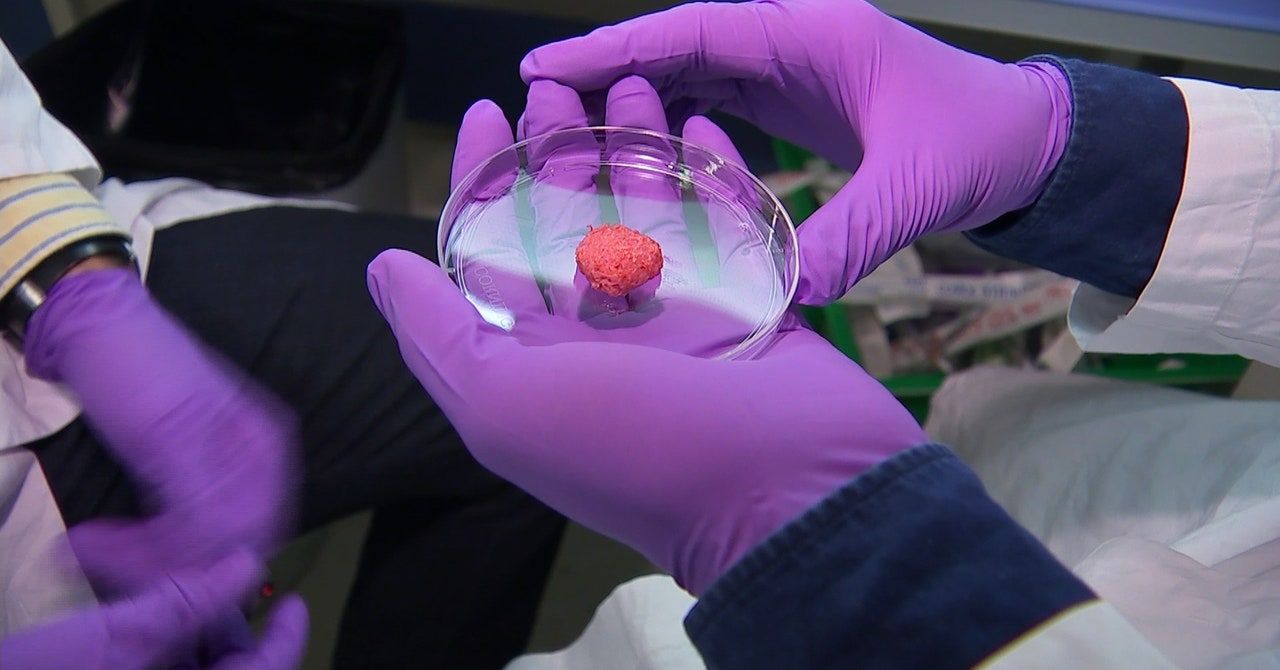

Pour certains il n'est qu'un escroc, pour d'autres il est le dernier représentant d'une famille politique grande gueule en voie d'extinction, pour nous il est un peu des deux, mais surtout un homme trop souvent caricaturé, la forme prenant le pas sur le fond. Pour remettre les pendules à l'heure, nous avons sélectionné ses 8 […]